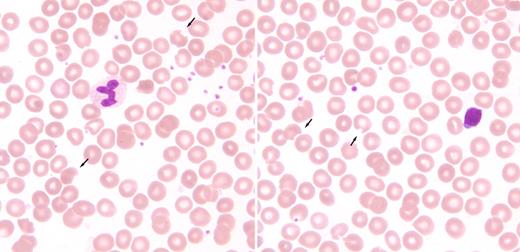
A 74-year-old white woman with lichen planus and hemoglobin 130g/L was started on 100 mg of dapsone daily. Within 2 weeks she developed progressive fatigue, shortness of breath on exertion, yellowing of her skin, and dark urine. By the time she was assessed and admitted to hospital approximately 4 weeks later, her hemoglobin was 75g/L with elevated LDH, reticulocyte count, and indirect bilirubin. She was otherwise healthy and was not on any other medications. There was no family history of anemia or G6PD deficiency. The antiglobulin test was negative, and a G6PD test was not ordered. The dapsone was discontinued and she received 3 units of red blood cell concentrates. One week later she was seen by hematology. The hemoglobin, reticulocyte count, and indirect bilirubin had returned to normal. The original peripheral blood smear was unavailable but the current smear showed “bite” cells (see arrows in figure). The direct antiglobulin test remained negative and Heinz bodies were not seen on supravital stains. The patient did not return for further assessment and G6PD testing. / Dapsone is an antibacterial agent used for infections such as Mycobacterium tuberulosis. It has anti-inflammatory and immunomodulatory properties that may be useful in various skin diseases such as lichen planus. Dapsone metabolites can lead to oxidative stress, denatured hemoglobin, and methemoglobinuria. Occasionally, “bite” cells can be seen on peripheral smears. Patients receiving dapsone should be assessed for evidence of hemolysis.

A 74-year-old white woman with lichen planus and hemoglobin 130g/L was started on 100 mg of dapsone daily. Within 2 weeks she developed progressive fatigue, shortness of breath on exertion, yellowing of her skin, and dark urine. By the time she was assessed and admitted to hospital approximately 4 weeks later, her hemoglobin was 75g/L with elevated LDH, reticulocyte count, and indirect bilirubin. She was otherwise healthy and was not on any other medications. There was no family history of anemia or G6PD deficiency. The antiglobulin test was negative, and a G6PD test was not ordered. The dapsone was discontinued and she received 3 units of red blood cell concentrates. One week later she was seen by hematology. The hemoglobin, reticulocyte count, and indirect bilirubin had returned to normal. The original peripheral blood smear was unavailable but the current smear showed “bite” cells (see arrows in figure). The direct antiglobulin test remained negative and Heinz bodies were not seen on supravital stains. The patient did not return for further assessment and G6PD testing.
Dapsone is an antibacterial agent used for infections such as Mycobacterium tuberulosis. It has anti-inflammatory and immunomodulatory properties that may be useful in various skin diseases such as lichen planus. Dapsone metabolites can lead to oxidative stress, denatured hemoglobin, and methemoglobinuria. Occasionally, “bite” cells can be seen on peripheral smears. Patients receiving dapsone should be assessed for evidence of hemolysis.
A 74-year-old white woman with lichen planus and hemoglobin 130g/L was started on 100 mg of dapsone daily. Within 2 weeks she developed progressive fatigue, shortness of breath on exertion, yellowing of her skin, and dark urine. By the time she was assessed and admitted to hospital approximately 4 weeks later, her hemoglobin was 75g/L with elevated LDH, reticulocyte count, and indirect bilirubin. She was otherwise healthy and was not on any other medications. There was no family history of anemia or G6PD deficiency. The antiglobulin test was negative, and a G6PD test was not ordered. The dapsone was discontinued and she received 3 units of red blood cell concentrates. One week later she was seen by hematology. The hemoglobin, reticulocyte count, and indirect bilirubin had returned to normal. The original peripheral blood smear was unavailable but the current smear showed “bite” cells (see arrows in figure). The direct antiglobulin test remained negative and Heinz bodies were not seen on supravital stains. The patient did not return for further assessment and G6PD testing.
Dapsone is an antibacterial agent used for infections such as Mycobacterium tuberulosis. It has anti-inflammatory and immunomodulatory properties that may be useful in various skin diseases such as lichen planus. Dapsone metabolites can lead to oxidative stress, denatured hemoglobin, and methemoglobinuria. Occasionally, “bite” cells can be seen on peripheral smears. Patients receiving dapsone should be assessed for evidence of hemolysis.
For additional images, visit the ASH IMAGE BANK, a reference and teaching tool that is continually updated with new atlas and case study images. For more information visit http://imagebank.hematology.org.

This feature is available to Subscribers Only
Sign In or Create an Account Close Modal